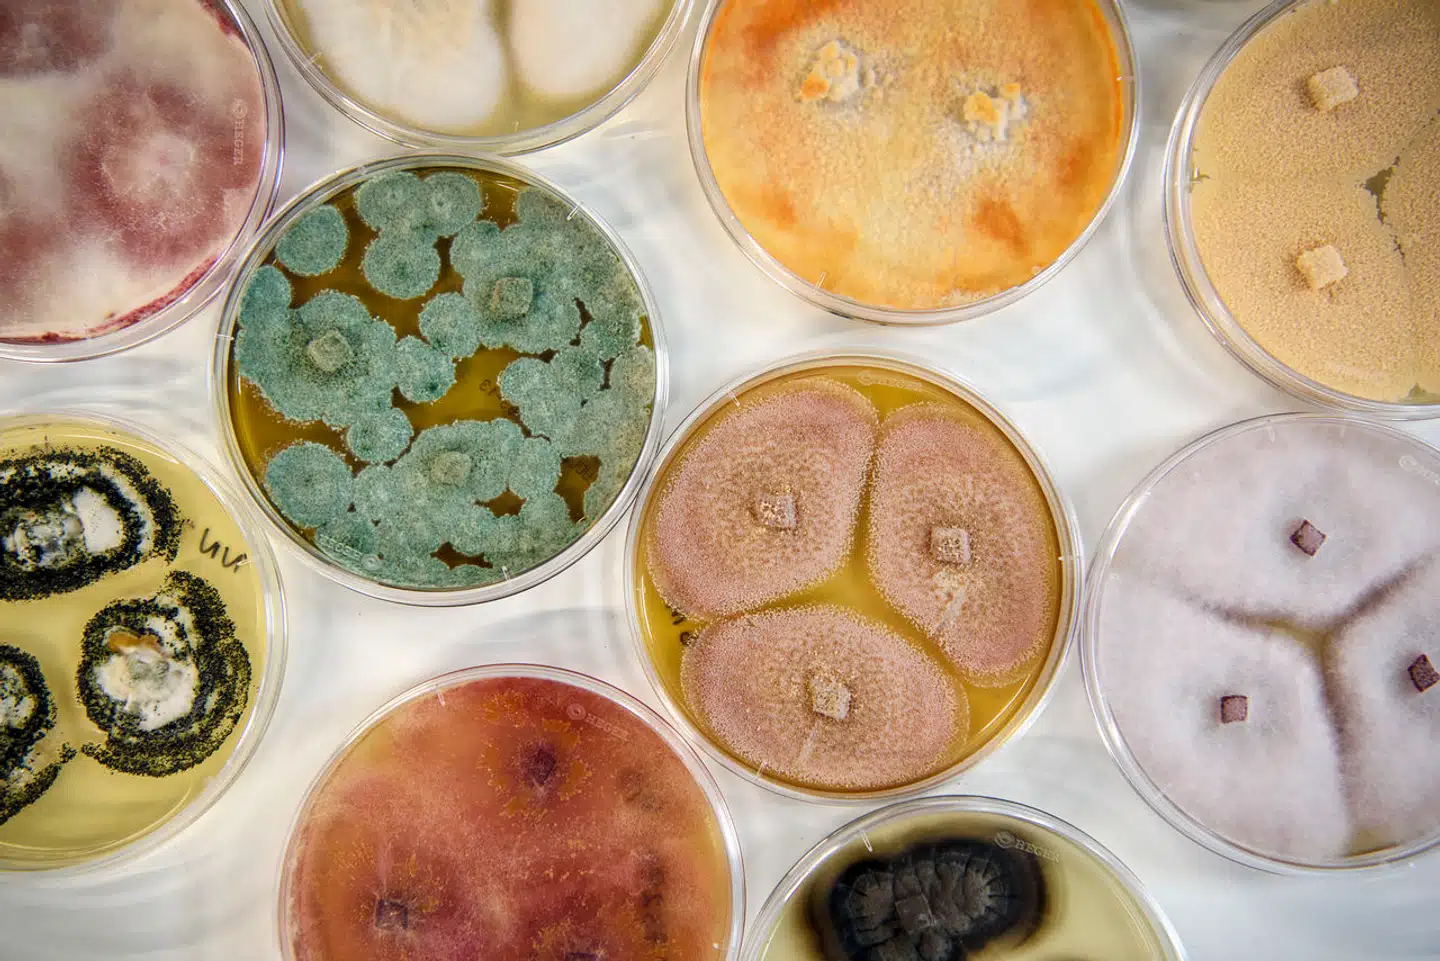
De to producenter af forskellige ingredienser, Novozymes og Chr. Hansen, er netop fusioneret til Novonesis, som lægger fra kaj med et brev, der har gjort flere leverandører ret utilfredse.

Godmorgen og velkommen til det første Business-overblik i en ny uge.
I dag runder vi blandt andet:
Podimo har en kvart million lyttere – nu går de efter en million
Hundredtusinder får nu beslaglagt del af lønnen
Hos revisionsgigant bestemmer de selv, om de vil komme på arbejde
Tyves nye guldgrube koster bilejere tusinder af kroner
Men vi begynder med en noget usædvanlig begyndelse for en ny dansk storfusion.
God læselyst, og følg med dagen igennem på Berlingske Business!
Dagens hovedhistorie
Ny kæmpefusion sender »uanstændigt« og »frækt« brev til leverandører
Kort efter kæmpefusionen mellem ingrediens- og enzymproducenterne Novozymes og Chr. Hansen – der blev samlet under navnet Novonesis – har leverandørerne nu fået et brev, hvori de opfordres til at sænke deres priser og udskyde leveringsfrister. Det er uacceptabelt og dårlig stil, mener revisionsekspert Kaj Glochau, mens SMVdanmark over for Finans kalder det »uanstændigt«. En unavngiven leverandør betragter det direkte som »frækt«.
I brevet står: »Vi forventer bidrag fra alle vores leverandører og beder venligst jer om at vurdere muligheden for at reducere jeres priser med 8 pct. og udvide jeres betalingsvilkår til over 90 dage.«
Kaj Glochau mener, at det kan presse små og mellemstore virksomheders likviditet, når de bliver presset på udskudte betalinger.
»Jeg synes hverken, det er pænt eller klogt at bruge en fusion som løftestang for at forlænge betalingsbetingelserne. De ‘heldige’ leverandører kan jo selv vælge at sige nej tak og finde en anden kunde, mens de pressede leverandører så må acceptere at blive endnu mere pressede,« siger han til Finans.
Novonesis kommunikationschef, Lina Danstrup, forklarer, at det er et forsøg på at se, om fusionen kan føre til »nye muligheder for øget skala og effektivitet« og kalder det »almindelig praksis«. Men »hverken pris eller betalingsbetingelser bliver ændret for vores leverandører uden foregående aftale«, lover hun.
Det skriver andre medier om
1. Podimo har en kvart million lyttere – nu går de efter en million
Podcasttjenesten Podimo har indfriet det mål, som blev sat sig i 2019, og går derfor nu efter at firdoble lytterantallet, skriver Finans. »Vi går mere i retning af TV 2 Play i størrelse,« siger medstifter Morten Strunge og uddyber, at det betyder omkring en million abonnenter. Tjenesten er gået fra et lille kontor til i dag at beskæftige 250 ansatte i syv forskellige lande og hente 1,5 milliarder kroner i investeringer fra kapitalfonde.
2. Hundredtusinder får nu beslaglagt del af lønnen
Over en kvart million danskere får nu beslaglagt en del af lønnen hver måned, efter at Gældsstyrelsen siden 1. oktober 2023 har haft lov til at tage op til 60 procent af nettoindkomsten hos dem, der skylder det offentlige penge. Det gælder også dem, der i forvejen afdrager deres gæld, skriver Politiken. Danskerne skylder det offentlige mere end 150 milliarder kroner. Gældsrådgivningen hos Forbrugerrådet Tænk har fået markant flere henvendelser siden ændringen. Samme mønster ses hos KFUMs Sociale Arbejde, der tilbyder frivillig gældsrådgivning, skriver TV 2.
3. Tyves nye guldgrube koster bilejere tusinder af kroner
Biltyve har fundet en ny guldgrube, der kan koste bilejerne tusinder af kroner, uden at de kan stille noget op. De stjæler sidespejle, som indeholder avanceret teknologi som varmetråde, nedblænding og radarsystemer, og det har især ramt ejere af dyrere biler som Audi, Tesla, BMW og Mercedes, skriver TV 2. Områdechef i FDMs tekniske rådgivning Lone Otto anslår, at glassene koster 2.000-4.000 kroner, men bliver ledningerne ødelagt under tyveriet, fordobles regningen typisk.
Det skriver vi om
1. Hos revisionsgigant bestemmer de selv, om de vil komme på arbejde
I det danske hovedkvarter for det internationale revisions- og konsulenthus EY har de ansatte frit spil for, om de vil passe deres job derhjemme, i sommerhuset eller møde op på kontoret. »Man kan arbejde fra hvor som helst,« siger hr-direktør Peter Haugaard. Læs historien her.
2. Professor forsvarer ATP i strid om forvaltning af tvungne pensionsmilliarder
Der bliver kastet tunge sten efter danskernes tvungne pensionsopsparing for tiden. Finansekspert mener, at det er en overreaktion, og at kritikken mod ATP i virkeligheden skal rettes et helt andet sted hen. Læs historien her.
Det bør du også læse
Er kunstig intelligens en ven eller fjende? Direktør har råd til dig, som står for skud, når ai overtager job
Verden over buldrer brugen af kunstig intelligens frem, og teknologien truer med at overtage arbejdspladser på tværs af brancher. Nogle job vil forsvinde og forandre sig. Men det er ikke nødvendigvis kun skidt, og direktør giver tip til dem, hvis job er i fare. Læs historien her.
Det sker på markederne
Aktier – indeks og udvikling i procent
USA – lukkekurser fredag:
Dow Jones: -0,37 procent
S&P 500: -0,48 procent
Nasdaq: -0,82 procent
Asien – indeks mandag kl. 7.00:
Japan Nikkei: -0,10 procent
Hongkong Hang Seng: -0,97 procent
Kina CSI Shanghai: +0,96 procent
Tak, fordi du læste med!
Venlig hilsen
Theresa Thrue Heiredal, Business-journalist
Thomas Breinstrup, Business-journalist